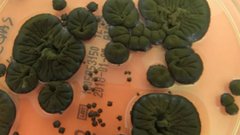
В зоне Чернобыля нашли уникальный гриб-пожиратель радиации

Звери. Главное
12.12.2024, 16:50
Свидетели заметили кольчатую нерпу недалеко от Салехарда, которая, вероятно, сбилась с пути в процессе охоты.
31.07.2024, 16:27
Сотрудница департамента природных ресурсов ЯНАО поделилась кадрами, снятыми на фотоаппарат в "Ингилоре".
18.07.2024, 16:46
На территории Надыма был замечен медвежонок.
Реклама
Мы рекомендуем
По информации Bloomberg, Индия планирует взять в аренду атомную подводную лодку у России.
04.12.2025, 15:24
Тотальные блокировки многочисленных иностранных интернет-сервисов могут иметь смысл только в случае наличия российских альтернатив.
04.12.2025, 13:29
04.12.2025, 11:36
Реклама
Интервью
Видео
Видео



















